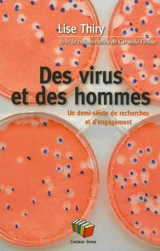
Des virus et des hommes : un demi-siècle de recherches et d'engagements - Lise Thiry

La science et le chercheur : les chemins du doute
Lise Thiry
Labor, Centre d'action laïque (Editions du)
|
février 2005
1.90 €
-5% pour les titulaires de la carte
info
avec le retrait en librairie
LIBRAIRIES PARTICIPANTES
Paris VIᵉ, Paris VIIIᵉ, Paris XVIIᵉ, Paris Vᵉ
Versailles, Lyon 2ᵉ, Lyon 6ᵉ...
Versailles, Lyon 2ᵉ, Lyon 6ᵉ...
Voir les disponibilités en librairie
RésuméUn plaidoyer pour que les jeunes chercheurs bénéficient d'un crédit de vagabondage à l'exemple des grands inventeurs et pour qu'ils sachent retrouver le pouvoir du doute contre leurs propres inventions et découvertes. ©Electre 2026 |
Caractéristiques Auteur(s) Éditeur(s) Date de parution
12 février 2005
Collection(s)
Liberté, j'écris ton nom
Rayon
Sciences généralités
EAN
9782804019969
Nombre de pages
90
pages
Reliure
Broché
Dimensions
22.0
cm x
12.0
cm x
0.6
cm
Poids
136
g
|